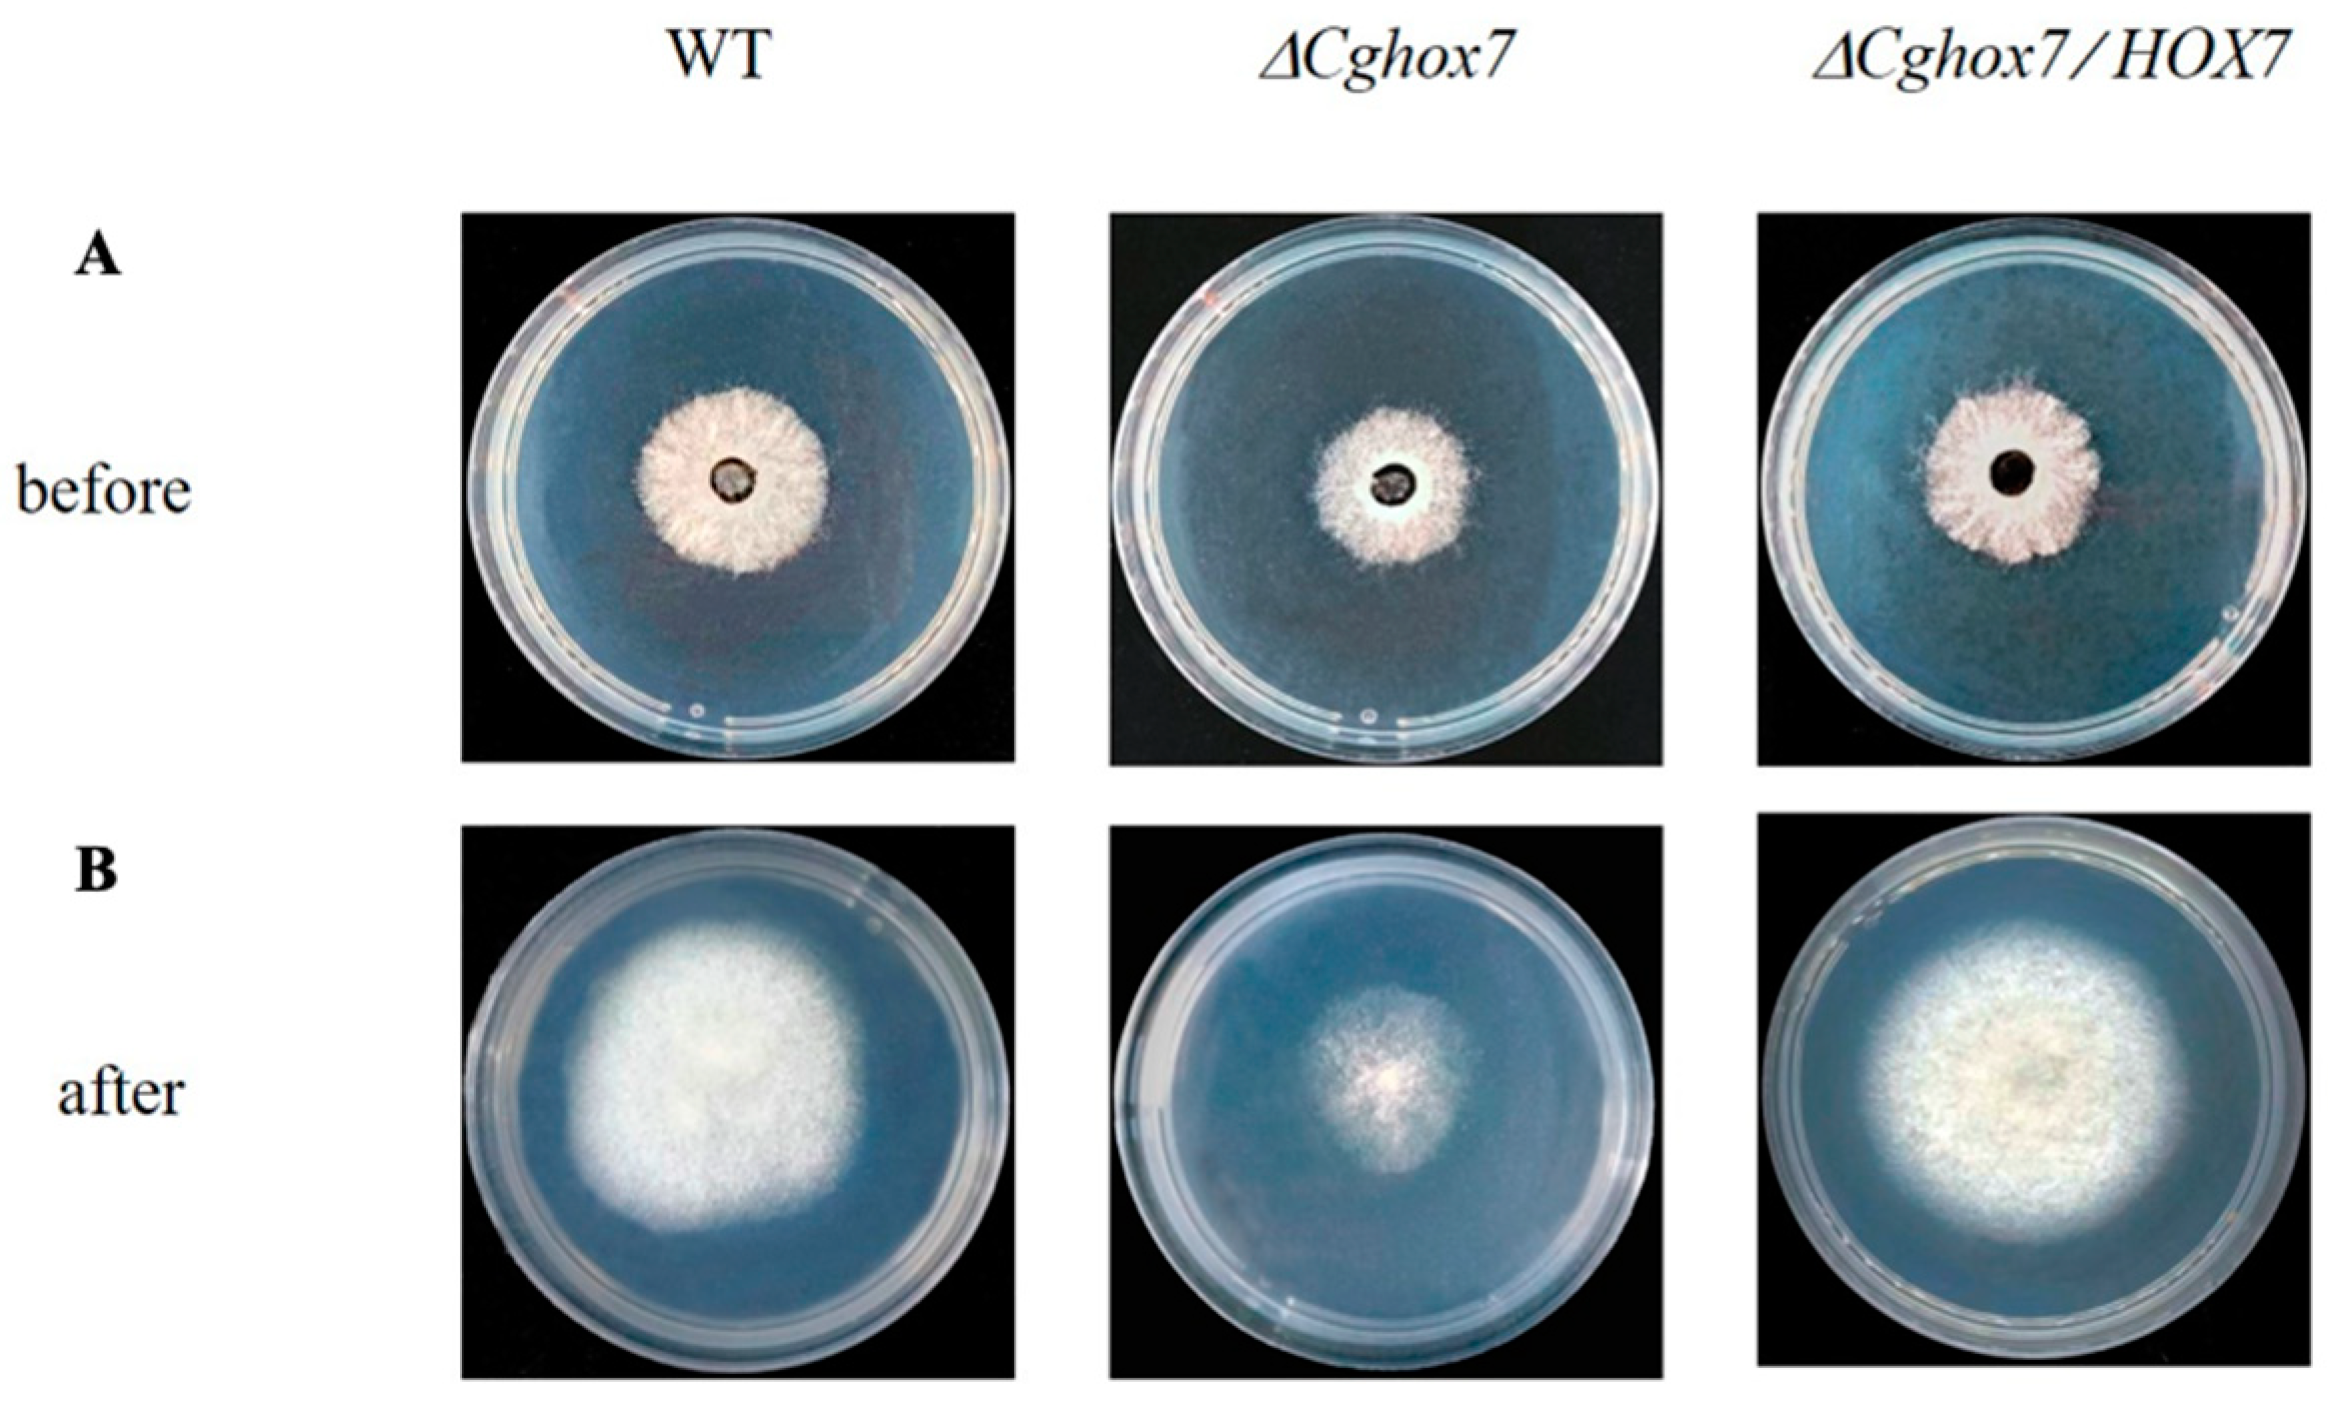
Jof 10 00505 g004

Functional Characterization of the Transcription Factor Gene CgHox7 in Colletotrichum gloeosporioides, Which Is Responsible for Poplar Anthracnose
Abstract
1. Introduction
2. Materials and Methods
2.1. Fungal Strains and Culture Conditions
2.2. Bioinformatics Analysis of CgHox7
2.3. Targeted Gene Knockout and Complementation
2.4. Conidial Germination and Appressorium Formation
2.5. Cellophane Membrane Penetration Assay
2.6. Pathogenicity Assay
2.7. Stress Sensitivity Assay
2.8. ROS Staining Assay
3. Results
3.1. Characterization and Deletion of CgHox7 in C. gloeosporioides
3.2. CgHox7 Does Not Regulate Hyphal Vegetative Growth
3.3. CgHox7 Is Essential for Appressorium Formation and Maturation
3.4. CgHox7 Regulates the Penetration Ability of Hyphae
3.5. Disruption of CgHox7 Results in a Loss of Virulence
3.6. CgHox7 Is Required for Cell Wall Integrity
3.7. Deletion of CgHox7 Affects the Oxidative Stress Response
3.8. ROS Accumulation during Conidial Germination Is Affected by the Deletion of CgHox7
4. Discussion
Supplementary Materials
Author Contributions
Funding
Institutional Review Board Statement
Informed Consent Statement
Data Availability Statement
Conflicts of Interest
References
- Flaishman, M.A.; Hwang, C.S.; Kolattukudy, P.E. Involvement of protein phosphorylation in the induction of appressorium formation in Colletotrichum gloeosporioides by its host surface wax and ethylene. Physiol. Mol. Plant Pathol. 1995, 47, 103–117. [Google Scholar] [CrossRef]
- Kim, S.; Park, S.Y.; Kim, K.S.; Rho, H.S.; Chi, M.H.; Choi, J.; Park, J.; Kong, S.; Park, J.; Goh, J.; et al. Homeobox transcription factors are required for conidiation and appressorium development in the rice blast fungus Magnaporthe oryzae. PLoS Genet. 2009, 5, e1000757. [Google Scholar] [CrossRef] [PubMed]
- Li, Z.; Liang, Y.M.; Tian, C.M. Characterization of the causal agent of poplar anthracnose occurring in the Beijing region. Mycotaxon 2012, 120, 277–286. [Google Scholar] [CrossRef]
- Kleemann, J.; Rincon-Rivera, L.J.; Takahara, H.; Neumann, U.; Van Themaat, E.V.; van Der Does, H.C.; Hacquard, S.; Stüber, K.; Will, I.; Schmalenbach, W.; et al. Sequential delivery of host-induced virulence effectors by appressoria and intracellular hyphae of the phytopathogen Colletotrichum higginsianum. PLoS Pathog. 2012, 8, e1002643. [Google Scholar] [CrossRef]
- Zhang, X.L.; Zhang, J.; He-Pu, H.Z.; Wang, X.L.; Tian, C.M. Histopathology study of poplar leaves infected by Colletotrichum gloeosporioides. J. Beijing For. Univ. 2018, 40, 101–109. [Google Scholar]
- Jiang, C.; Zhang, X.; Liu, H.; Xu, J.-R. Mitogen-activated protein kinase signaling in plant pathogenic fungi. PLoS Pathog. 2018, 14, e1006875. [Google Scholar] [CrossRef] [PubMed]
- Sakulkoo, W.; Osés-Ruiz, M.; Garcia, E.O.; Soanes, D.M.; Littlejohn, G.R.; Hacker, C.; Correia, A.; Valent, B.; Talbot, N.J. A single fungal MAP kinase controls plant cell-to-cell invasion by the rice blast fungus. Science 2018, 359, 1399–1403. [Google Scholar] [CrossRef] [PubMed]
- Marroquin-Guzman, M.; Wilson, R.A. GATA-dependent glutaminolysis drives appressorium formation in Magnaporthe oryzae by suppressing TOR inhibition of cAMP/PKA signaling. PLoS Pathog. 2015, 11, e1004851. [Google Scholar] [CrossRef]
- Huang, P.; Wang, J.; Li, Y.; Wang, Q.; Huang, Z.; Qian, H.; Liu, X.-H.; Lin, F.-C.; Lu, J. Transcription factors Vrf1 and Hox7 coordinately regulate appressorium maturation in the rice blast fungus Magnaporthe oryzae. Microbiol. Res. 2022, 263, 127141. [Google Scholar] [CrossRef]
- He, P.; Wang, Y.; Wang, X.; Zhang, X.; Tian, C. The mitogen-activated protein kinase CgMK1 governs appressorium formation, melanin synthesis, and plant infection of Colletotrichum gloeosporioides. Front. Microbiol. 2017, 8, 2216. [Google Scholar] [CrossRef]
- Wang, X.; Lu, D.; Tian, C. Mitogen-activated protein kinase cascade CgSte50-Ste11-Ste7-Mk1 regulates infection-related morphogenesis in the poplar anthracnose fungus Colletotrichum gloeosporioides. Microbiol. Res. 2021, 248, 126748. [Google Scholar] [CrossRef]
- Li, F.; Lu, D.; Meng, F.; Tian, C. Transcription factor CgSte12 regulates pathogenicity by affecting appressorium structural development in the anthracnose-causing fungus Colletotrichum gloeosporioides. Phytopathology 2024. [Google Scholar] [CrossRef] [PubMed]
- Yokoyama, A.; Izumitsu, K.; Sumita, T.; Tanaka, C.; Irie, T.; Suzuki, K. Homeobox transcription factor CoHox3 is essential for appressorium formation in the plant pathogenic fungus Colletotrichum orbiculare. Mycoscience 2018, 59, 353–362. [Google Scholar] [CrossRef]
- Osés-Ruiz, M.; Cruz-Mireles, N.; Martin-Urdiroz, M.; Soanes, D.M.; Eseola, A.B.; Tang, B.; Derbyshire, P.; Nielsen, M.; Cheema, J.; Were, V.; et al. Appressorium-mediated plant infection by Magnaporthe oryzae is regulated by a Pmk1-dependent hierarchical transcriptional network. Nat. Microbiol. 2021, 6, 1383–1397. [Google Scholar] [CrossRef] [PubMed]
- Meng, F.; Tian, C. Gene family expansion during the adaptation of Colletotrichum gloeosporioides to woody plants. J. Fungi 2023, 9, 1185. [Google Scholar] [CrossRef] [PubMed]
- Wilson, R.A.; Gibson, R.P.; Quispe, C.F.; Littlechild, J.A.; Talbot, N.J. An NADPH-dependent genetic switch regulates plant infection by the rice blast fungus. Proc. Natl. Acad. Sci. USA 2010, 107, 21902–21907. [Google Scholar] [CrossRef] [PubMed]
- Apostol, I.; Heinstein, P.F.; Low, P.S. Rapid stimulation of an oxidative burst during elicitation of cultured plant cells: Role in defense and signal transduction. Plant Physiol. 1989, 90, 109–116. [Google Scholar] [CrossRef]
- Egan, M.J.; Wang, Z.Y.; Jones, M.A.; Smirnoff, N.; Talbot, N.J. Generation of reactive oxygen species by fungal NADPH oxidases is required for rice blast disease. Proc Natl Acad Sci. 2007, 104, 11772. [Google Scholar] [CrossRef]
- Shinogi, T.; Suzuki, T.; Kurihara, T.; Narusaka, Y.; Park, P. Microscopic detection of reactive oxygen species generation in the compatible and incompatible interactions of Alternaria alternata Japanese pear pathotype and host plants. J Gen Plant Pathol. 2003, 69, 7–16. [Google Scholar] [CrossRef]
- Voisey, C.R.; Christensen, M.T.; Johnson, L.J.; Forester, N.T.; Gagic, M.; Bryan, G.T.; Johnson, R.D. cAMP signaling regulates synchronised growth of symbiotic Epichloë fungi with the host grass Lolium perenne. Front. Plant Sci. 2016, 7, 1546. [Google Scholar] [CrossRef]
- Arnaise, S.; Zickler, D.; Poisier, C.; Debuchy, R. pah1: A homeobox gene involved in hyphal morphology and microconidiogenesis in the filamentous ascomycete Podospora anserina. Mol. Microbiol. 2001, 39, 54–64. [Google Scholar] [CrossRef]
- Ruiz-Roldán, M.C.; Maier, F.J.; Schäfer, W. PTK1, a mitogen-activated-protein kinase gene, is required for conidiation, appressorium formation, and pathogenicity of Pyrenophora teres on barley. Mol. Plant-Microbe Interact. 2001, 14, 116–125. [Google Scholar] [CrossRef] [PubMed]
- Xu, J.R.; Hamer, J.E. MAP kinase and cAMP signaling regulate infection structure formation and pathogenic growth in the rice blast fungus Magnaporthe grisea. Genes Dev. 1996, 10, 2696–2706. [Google Scholar] [CrossRef] [PubMed]
- Gustin, M.C.; Albertyn, J.; Alexander, M.; Davenport, K. MAP kinase pathways in the yeast Saccharomyces cerevisiae. Microbiol. Mol. Biol. Rev. 1998, 62, 1264–1300. [Google Scholar] [CrossRef]
- Hamel, L.-P.; Nicole, M.-C.; Duplessis, S.; Ellis, B.E. Mitogen-activated protein kinase signaling in plant-interacting fungi: Distinct messages from conserved messengers. Plant Cell 2012, 24, 1327–1351. [Google Scholar] [CrossRef] [PubMed]
- Wilson, R.A.; Talbot, N.J. Under Pressure: Investigating the biology of plant infection by Magnaporthe oryzae. Nat. Rev. Microbiol. 2009, 7, 185–195. [Google Scholar] [CrossRef]
- Park, G.; Xue, C.; Zheng, L.; Lam, S.; Xu, J.-R. MST12 Regulates infectious growth but not appressorium formation in the rice blast fungus Magnaporthe grisea. Mol. Plant-Microbe Interact. 2002, 15, 183–192. [Google Scholar] [CrossRef] [PubMed]
- Lu, J.; Cao, H.; Zhang, L.; Huang, P.; Lin, F. Systematic analysis of Zn2Cys6 transcription factors required for development and pathogenicity by high-throughput gene knockout in the rice blast fungus. PLoS Pathog. 2014, 10, e1004432. [Google Scholar] [CrossRef] [PubMed]
- Kovtun, Y.; Chiu, W.-L.; Tena, G.; Sheen, J. Functional analysis of oxidative stress-activated mitogen-activated protein kinase cascade in plants. Proc. Natl. Acad. Sci. USA 2000, 97, 2940–2945. [Google Scholar] [CrossRef]
- McCubrey, J.A.; LaHair, M.M.; Franklin, R.A. Reactive oxygen species-induced activation of the MAP kinase signaling pathways. Antioxid. Redox Signal. 2006, 8, 1775–1789. [Google Scholar] [CrossRef]
- Apel, K.; Hirt, H. Reactive oxygen species: Metabolism, oxidative stress, and signal transduction. Annu. Rev. Plant Biol. 2004, 55, 373–399. [Google Scholar] [CrossRef] [PubMed]

Disclaimer/Publisher’s Note: The statements, opinions and data contained in all publications are solely those of the individual author(s) and contributor(s) and not of MDPI and/or the editor(s). MDPI and/or the editor(s) disclaim responsibility for any injury to people or property resulting from any ideas, methods, instructions or products referred to in the content. |
© 2024 by the authors. Licensee MDPI, Basel, Switzerland. This article is an open access article distributed under the terms and conditions of the Creative Commons Attribution (CC BY) license (https://creativecommons.org/licenses/by/4.0/).
Share and Cite
Huang, Q.; Li, F.; Meng, F. Functional Characterization of the Transcription Factor Gene CgHox7 in Colletotrichum gloeosporioides, Which Is Responsible for Poplar Anthracnose. J. Fungi 2024, 10, 505. https://doi.org/10.3390/jof10070505
Huang Q, Li F, Meng F. Functional Characterization of the Transcription Factor Gene CgHox7 in Colletotrichum gloeosporioides, Which Is Responsible for Poplar Anthracnose. Journal of Fungi. 2024; 10(7):505. https://doi.org/10.3390/jof10070505
Chicago/Turabian StyleHuang, Qiuyi, Fuhan Li, and Fanli Meng. 2024. "Functional Characterization of the Transcription Factor Gene CgHox7 in Colletotrichum gloeosporioides, Which Is Responsible for Poplar Anthracnose" Journal of Fungi 10, no. 7: 505. https://doi.org/10.3390/jof10070505
APA StyleHuang, Q., Li, F., & Meng, F. (2024). Functional Characterization of the Transcription Factor Gene CgHox7 in Colletotrichum gloeosporioides, Which Is Responsible for Poplar Anthracnose. Journal of Fungi, 10(7), 505. https://doi.org/10.3390/jof10070505

